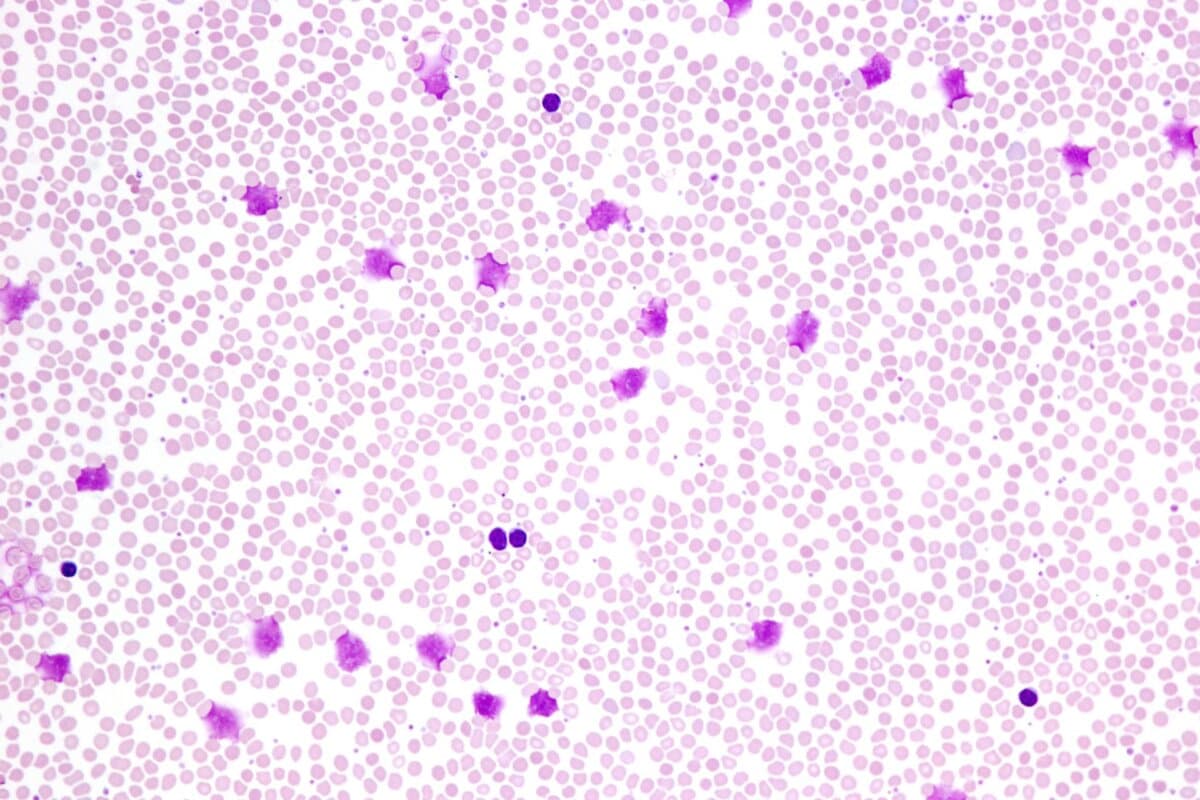

Acalabrutinib + Venetoclax: Neuer Standard in der CLL-Erstlinientherapie?
Die Kombination aus Acalabrutinib und Venetoclax, mit oder ohne Obinutuzumab, verlängert das progressionsfreie Überleben von therapienaiven CLL-Patienten. Beide Regime zeigten eine geringe Rate kardialer Ereignisse, wie auf dem 66. ASH Annual Meeting berichtet wurde.
JosLuis/stock.adobe.com
Die zeitlich begrenzte Therapie mit Ibrutinib und Venetoclax gilt als Standard für Patienten mit behandlungsbedürftiger chronischer lymphatischer Leukämie. Bruton-Tyrosinkinase-Inhibitoren (BTKi) der zweiten Generation versprechen dabei weniger kardiologische Nebenwirkungen als Ibrutinib.
Quelle
- Brown JR et al. 1009 Fixed-Duration Acalabrutinib Plus Venetoclax with or without Obinutuzumab Versus Chemoimmunotherapy for First-Line Treatment of Chronic Lymphocytic Leukemia: Interim Analysis of the Multicenter, Open-Label, Randomized, Phase 3 AMPLIFY Trial. 66th ASH Annual Meeting 2024; Abstract 1009